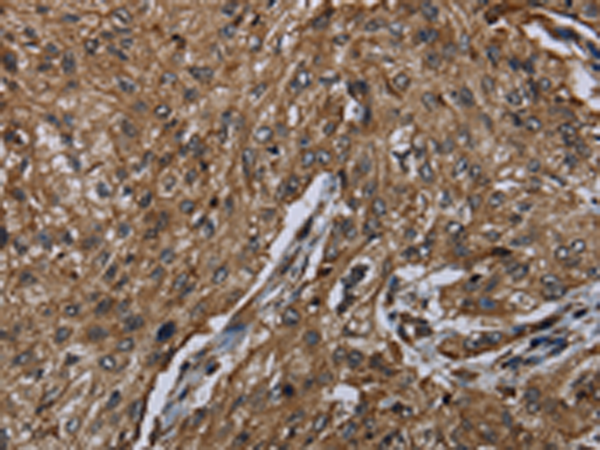

-
分类: 科研抗体货号: P08406别名: HPCL; HPCL2; PHYH2; 2-HPCL应用: WB,IHC反应种属: Human, Mouse, Rat
-
分类: 科研抗体货号: P08435别名: IL14; TXLN应用: WB,IHC反应种属: Human, Mouse
-
分类: 科研抗体货号: P08423别名: LUCA3; HYAL-3; LUCA-3应用: WB,IHC反应种属: Human, Rat
-
分类: 科研抗体货号: P08434别名: IKIP应用: IHC反应种属: Human, Mouse, Rat
-
分类: 科研抗体货号: P08439别名: P64; CIDX; IMD4; CD132; SCIDX; IL-2RG; SCIDX1应用: IHC反应种属: Human
-
分类: 科研抗体货号: P08422别名: LUCA2应用: IHC反应种属: Human, Mouse, Rat
-
分类: 科研抗体货号: P08432别名: BDA1; HHG2应用: IHC反应种属: Human, Mouse
-
分类: 科研抗体货号: P08438别名: IL28B; IL28C; IL-28B应用: WB反应种属: Human
-
分类: 科研抗体货号: P08450别名: NECC1; JAMIP2应用: IHC反应种属: Human
-
分类: 科研抗体货号: P08431别名: CD16; FCG3; CD16A; FCGR3; IGFR3; IMD20; FCR-10; FCRIII; FCGRIII; FCRIIIA应用: IHC反应种属: Human

鄂公网安备42018502007531号
鄂公网安备42018502007531号

